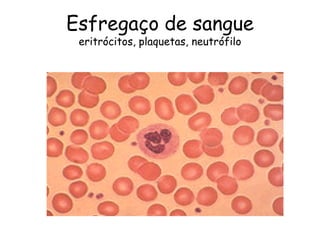
Esfregaço de sangue
 eritrócitos, plaquetas, neutrófilo

O documento discute propriedades do sangue e hematopoese. Aborda a composição do sangue, incluindo os tipos de células e suas quantidades no corpo humano adulto. Também explica o processo de hematopoese na medula óssea, onde as células-tronco hematopoéticas se desenvolvem em diferentes linhagens celulares do sangue sob a influência de citocinas.